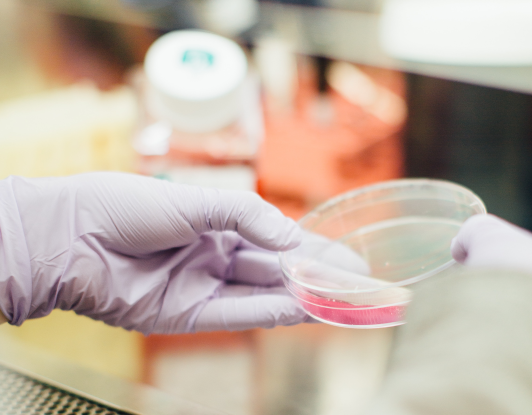

Op weg naar onze ascensie zijn we bezig met het afwerken van onze verdrongen emoties, met het opruimen van onze blokkades, onze innerlijke processen of thema’s zoals Jezus ze noemt. Hoewel elk mens uniek is, gaan we vaak door dezelfde processen. Daarom kunnen we veel leren van de thema’s van anderen en hoe die werden afgewerkt
Er komen regelmatig mensen om raad voor hun relationele problemen. Liefde is dat, wat we in werkelijkheid zijn, maar dan hebben we het over onvoorwaardelijke liefde en dat moeten we veelal nog vanuit onze kern activeren.
Deze man heeft net een relatie achter de rug en heeft een vrouw ontmoet waarvoor zijn hart weer open gaat.
Na een aura- en chakrareading, waarbij ik zag dat de wonden vanwege het afbreken van zijn vorige relaties nog niet geheeld waren, zei ik hem het volgende:
"Je hart is inderdaad weer even open gegaan, maar de wonden, die zijn ontstaan door het verbreken van je vorige relatie heb ik nog kunnen waarnemen. Je bent ook met dergelijke pijn in deze incarnatie gestapt, pijn uit verbroken relaties in andere levens.